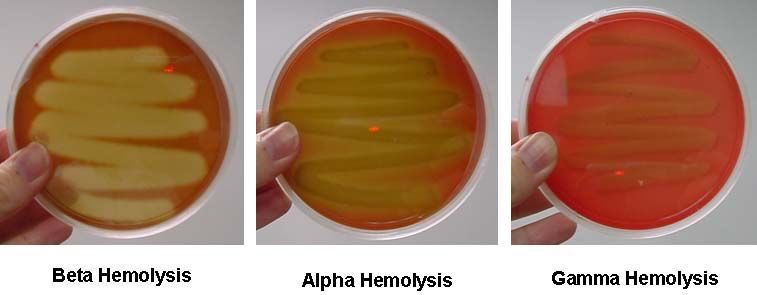

Beta.Imagefap
Nounanka Sedai
Massive Boobs Pictures
Sex Vídeos
Licked Pussy Young Girl
Spooge on my Girlfriend Leg
Indian House Wife Hidden Cam Sex Videos
Erection At Massage Gif
Bombshell malkova rubbed down fucked masseur photo
Pantyhose lesbian anal sex tgp gallery
Grandpa Shigeo With Young
Passion skye west trisha parks share best adult free images
My Ex Wife Lost And Found Sex Tape 1
Spank Strap
Beta.Imagefap 112 photos